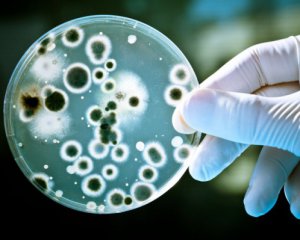
Люди могут заразить Марс

Научные работники NASA выдвинули уникальную гипотезу о Марсе.
Специалисты нашли способ, как обезопасить Красную планету от бактерий. В виду этого, под угрозой находились все экспедиции на звезде.
ЧИТАЙТЕ ТАКЖЕ: Назвали самое грязное место на кухне
По словам специалистов, бактерии могут оказать вред космическим просторам. Больше 10 лет назад, вид земных микробов Bacillus pumilus был фактически уничтожен. На сегодняшний день встретиться с этими бактериями можно только в условиях лабораторной деятельности. Об этом сообщает actualnews.
Ученые хранят организмы в вакуумных контейнерах. Для того, чтобы спасти Марс с другие планеты в космосе, эксперты задумались над созданием способа ликвидации опасных микроорганизмов. В рамках исследования, Bacillus pumilus запустили на воздушном шаре.
Спустя 8 часов после отправления, осталось лишь 0,001% спор бактерий. Космических вредителей можно убить с помощью ультрафиолетового излучения.
Космический зонд "Юнона" сделала зрелищное фото Большого темного пятна. Это одна из крупнейших бурей на Юпитере.
Комментарии
1